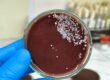

This post was originally published on here
Global investment
in consumer health tech is surging, according to Marketing Daily’s most-readhealth/pharma news story of 2025. But, said article source Gelen
Growth, the growth of new health tech ventures is being hurt by a “lack of proven clinical evidence.”
Established big pharma firms, meanwhile, offer lots of clinical evidence —
but these days can often be found battling skeptics.
In the year’s ninth most-read story, Pfizer CEO Albert Bourla back in February told analysts he
was “cautiously optimistic” about the prospect of anti-vaccine crusader Robert F. Kennedy Jr. becoming head of the U.S. department of Health & Human Services. Earlier this month, with
RFK Jr. now entrenched atop U.S. health policy, Bourla was singing a different
tune in a non-top-10 story covering another analyst call. “What is worrisome is that science is replaced with political beliefs or sometimes obsession,” he said.
advertisement
advertisement
“We
chase the miracles of science so you can chase your dreams,” bragged Sanofi in its new corporate campaign, which resulted in our no. 2 story of the year.
“Recently, we have seen an increase in people’s interest in health and science as they increasingly recognize the value of being equipped with information to inform their own health
decisions,” Sanofi told Marketing Daily.
Eli Lilly, meanwhile, turned the tables on the science-deniers with a corporate campaign declaring, “Be a Healthy Skeptic.” Coming in at no. 7 on our Top 10 list, the
story included Lilly telling Marketing Daily that “Questioning whether something actually works is how we get to repeatable, peer-reviewed proof that a medicine is safe and
effective.”
The Lilly campaign, which came down hard on marketers of compounded drugs, followed Hims & Hers’ controversial Super Bowl commercial, which had stated
that the telehealth company’s compounded GLP-1 weight loss medications were “affordable,” and “doctor trusted” while big pharma’s were “priced for profits,
not patients.” Marketing’s Daily’scoverage of that
commercial garnered the no. 4 spot on our top 10 list.
Another telehealth marketer of compounded meds, Rugiet, came in at no. 3 for a story about the launch of “Go Long,” its provocatively named treatment for erectile disfunction.
Only
one pharma ad campaign made the top 10: UCB’s inaugural push for
Zilbrysq (no. 8), which treats myasthenia gravis, a rare neurological disease.
Three over-the-counter brands round out the top 10 list, all for non-traditional marketing efforts:
At no. 5, Opella’s Aspercreme pain relief brand announced a 58-year-old freshman as the oldest college football player ever to sign an NIL (name, image and likeness)
deal.
At no. 6, Reckitt’s Mucinex unveiled an experiential 3D art
installation in New York’s Grand Central Station to launch its new Clear and Cool Saline Nasal Spray.
Finally, circling back to the power of science , comes Kimberly-Clark’s
Poise at no. 10. Our story covered how the bladder leak protection brand is working with scientists to determine if dry urine extracted from used pads could become “Drops of Hope” to detect urinary tract infections, diabetes and other
conditions in perimenopausal and menopausal women, especially for rural women in “health deserts.”